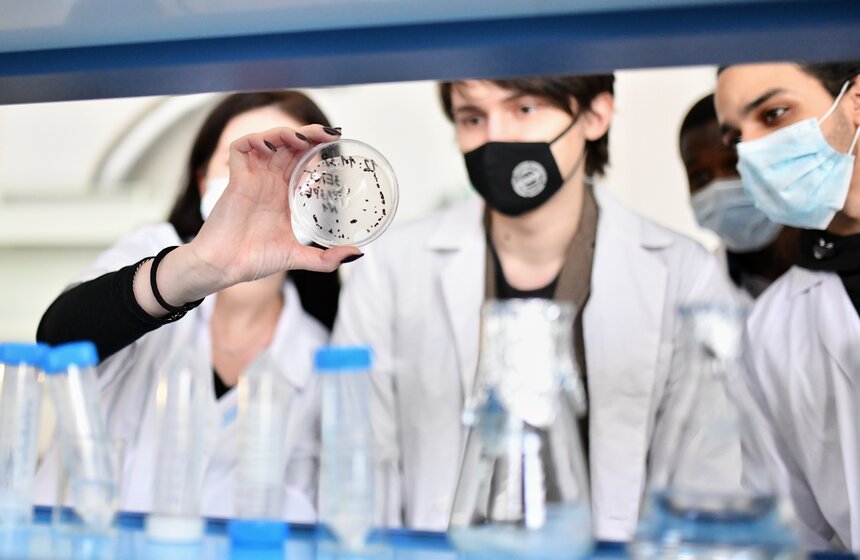
Студенты РУДН вернулись к очному обучению 24 фото

09 февраля 2021, 10:00
ОбществоСтуденты РУДН вернулись к очному обучению
РУДН вернулся к очному обучению. С 8 февраля студенты Российского университета дружбы народов вернулись в аудитории. Часть дисциплин осталась в онлайн – это потоковые лекции и те дисциплины, которые читают преподаватели старше 65 лет.
Сейчас учебные аудитории заполнены на 50%. Для этого занятия проводятся в несколько смен. Для соблюдения рекомендаций Роспотребнадзора в РУДН обучен волонтерский отряд. Студенты измеряют температуру тела, контролируют масочный режим и помогают соблюдать социальную дистанцию.
С 13 ноября Минобрнауки предписало всем руководителям подведомственных вузов Москвы и Санкт-Петербурга перевести студентов на дистанционное обучение. С этого же дня студенты и колледжи столицы ушли на дистанционку по указу Сергея Собянина. Региональным вузам было рекомендовано решать этот вопрос с местными органами Роспотребнадзора.
На прошлой неделе Собянин заявил, что в связи с улучшением эпидемиологической ситуации столичные студенты вернутся к очному обучению с 8 февраля. С этого же дня будут разблокированы все транспортные карты учащихся.
С 22 января к очному формату обучения вернулись московские колледжи, учреждения допобразования, спортивные школы и детские досуговые учреждения, а с 18 января с дистанционки вышли школьники. Всего в столичные школы вернулись более миллиона детей.
Фото: Москва 24/Юлия Иванко








 Собянин: школу будущего в Пресненском районе выполнят в футуристическом стиле
Собянин: школу будущего в Пресненском районе выполнят в футуристическом стиле